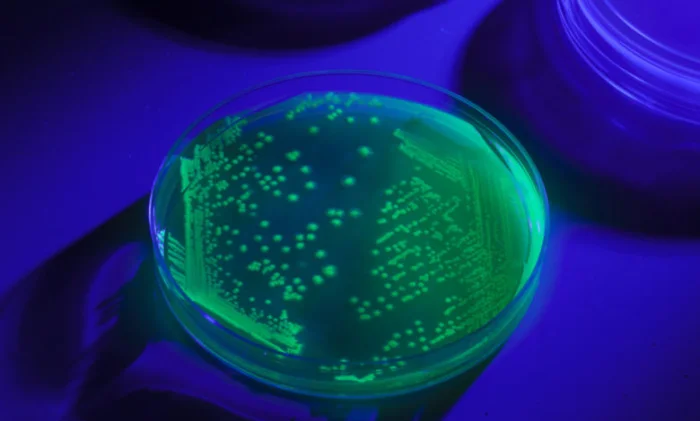

Как учёные заглянули в клетку, чтобы улучшить лекарства
html Копировать Скачать Запустить
Знаете это чувство, когда метод тыка начинает бесить? Особенно если цена ошибки — здоровье и время. В разработке лекарств такого добра хватает: нужную молекулу-линкер (это такой «клей» между антителом и лекарством) часто искали вслепую, перебирая варианты. Но, кажется, в Корнелльском университете нашли способ внести в этот процесс немного науки и много точности. И теперь они могут заглянуть внутрь живой клетки и подсмотреть, как там на самом деле работает эта связка.
Если совсем просто: представьте себе антитело как ищейку, которая должна найти раковую клетку и притащить ей «подарок» — лекарство. Линкер в этой схеме — поводок. Но поводок должен не просто держать лекарство, пока они плывут к цели. Ему нужно в нужный момент, прямо внутри клетки, этот поводок развязать, чтобы лекарство вышло на свободу. И вот тут начинаются проблемы: раньше эффективность таких линкеров проверяли в пробирке, в чистеньких модельных растворах. А клетка — это вам не пробирка. Там бардак, куча взаимодействий, и идеальный в теории линкер в реальности мог просто «залипнуть» и ничего не отпустить.
Команда под руководством Криса Алаби решила эту несправедливость. Они придумали методику, которая позволяет в прямом смысле увидеть, как линкер делает свою работу внутри живой клетки. Секрет — в хитрых флуоресцентных зондах. По сути, они прицепили к системе доставки два красителя, которые, пока всё хорошо, «гасят» друг друга. Как только линкер внутри клетки разрушается и красители расходятся, они начинают светиться под микроскопом. Это сигнал: «Всё сработало, лекарство вышло!». Согласитесь, смотреть на такие вещи вживую — это уже не метод тыка, а высший пилотаж.
«Прямо сейчас фармацевтические компании создают тонну линкеров, а затем проверяют, какие функции лучше всего подходят для конкретного применения, проверяя каждое из них. Это подход с дробовиком», — сказал Алаби. «С нашей техникой они могут теперь принять обоснованное решение, основанное на фактических внутриклеточных числах, прежде чем они соединят лекарственную систему».
То есть, можно будет не гадать на кофейной гуще, а просто посмотреть: вот этот линкер разваливается за 10 минут, а этот — за час. И уже подбирать его под конкретную задачу.
Красота этого подхода в том, что он даёт не просто картинку, а цифры. Можно точно измерить скорость, с которой химическая связь линкера рвётся внутри клетки. Это уже не качественная оценка «работает — не работает», а чистая математика.
«Как только мы узнаем, какое время выбрано для различных линкерных связей и клеточных процессов, мы можем сказать: «Хорошо, для препарата А, связанного с антителом В, это время, которое потребуется, поэтому, если мы хотим лечить болезнь С, мы следует использовать этот линкер», — пояснил Алаби.
Чтобы проверить свою разработку, учёные взяли классику — антитело к белку HER2, который давно стал мишенью номер один при лечении рака молочной железы. Они «привязали» его к лекарству через дисульфидный линкер (о котором уже было известно, что он в целом рабочий). И — о чудо — система позволила чётко замерить, с какой скоростью линкер разрушается и как долго живёт внутри клетки. Никаких догадок, только факты.
«Для биомолекулярных инженеров и компаний, которые ставят перед собой цель, мы можем… сделать процесс открытия лекарств намного быстрее, потому что теперь мы знаем кое-что о том, сколько времени потребуется, чтобы выпустить препарат», — резюмирует Алаби, который уже ищет партнёров среди фармгигантов.
И это, кстати, открывает дорогу не только для разработки лекарств. Химические биологи теперь могут использовать такие зонды, чтобы просто лучше понимать, как устроена жизнь внутри клетки. Например, какие именно молекулы отвечают за то, чтобы «перекусить» линкер? В общем, методика оказалась полезной сразу на двух фронтах: и для прикладных задач, и для фундаментальной науки. А это дорогого стоит.
Источник: phys.org